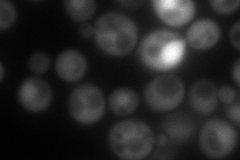
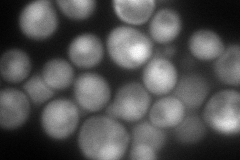
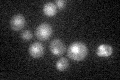

View description
Protein with a potential role in pre-rRNA processing
Localization:
Intensity:
Fold change:
Significance:
-
C’ GFP library in SD

nucleus:cytosol58 -
N' NOP1pr-GFP in SD
cytosol,nucleus134.474 -
N' TEF2pr-mCherry in SD
nucleus164.467 -
N' NATIVEpr-GFP in SD

nucleus42.0945 -
N' TEF2pr-VC and Cyto-VN in SD

cytosol,nucleus62.9252 -
C’ GFP library in SD+DTT

nucleus.cytosol37.040.63No -
C’ GFP library in SD+H2O2

nucleus.cytosol42.40.73No -
C’ GFP library in Starvation Media
nucleus,cytosol27.270.47Yes -
C’ GFP library on the background of Pup2-DaMP

nucleus:cytosol -
C’ GFP library on the background of CCT mutant

nucleus:cytosol58.00511No
